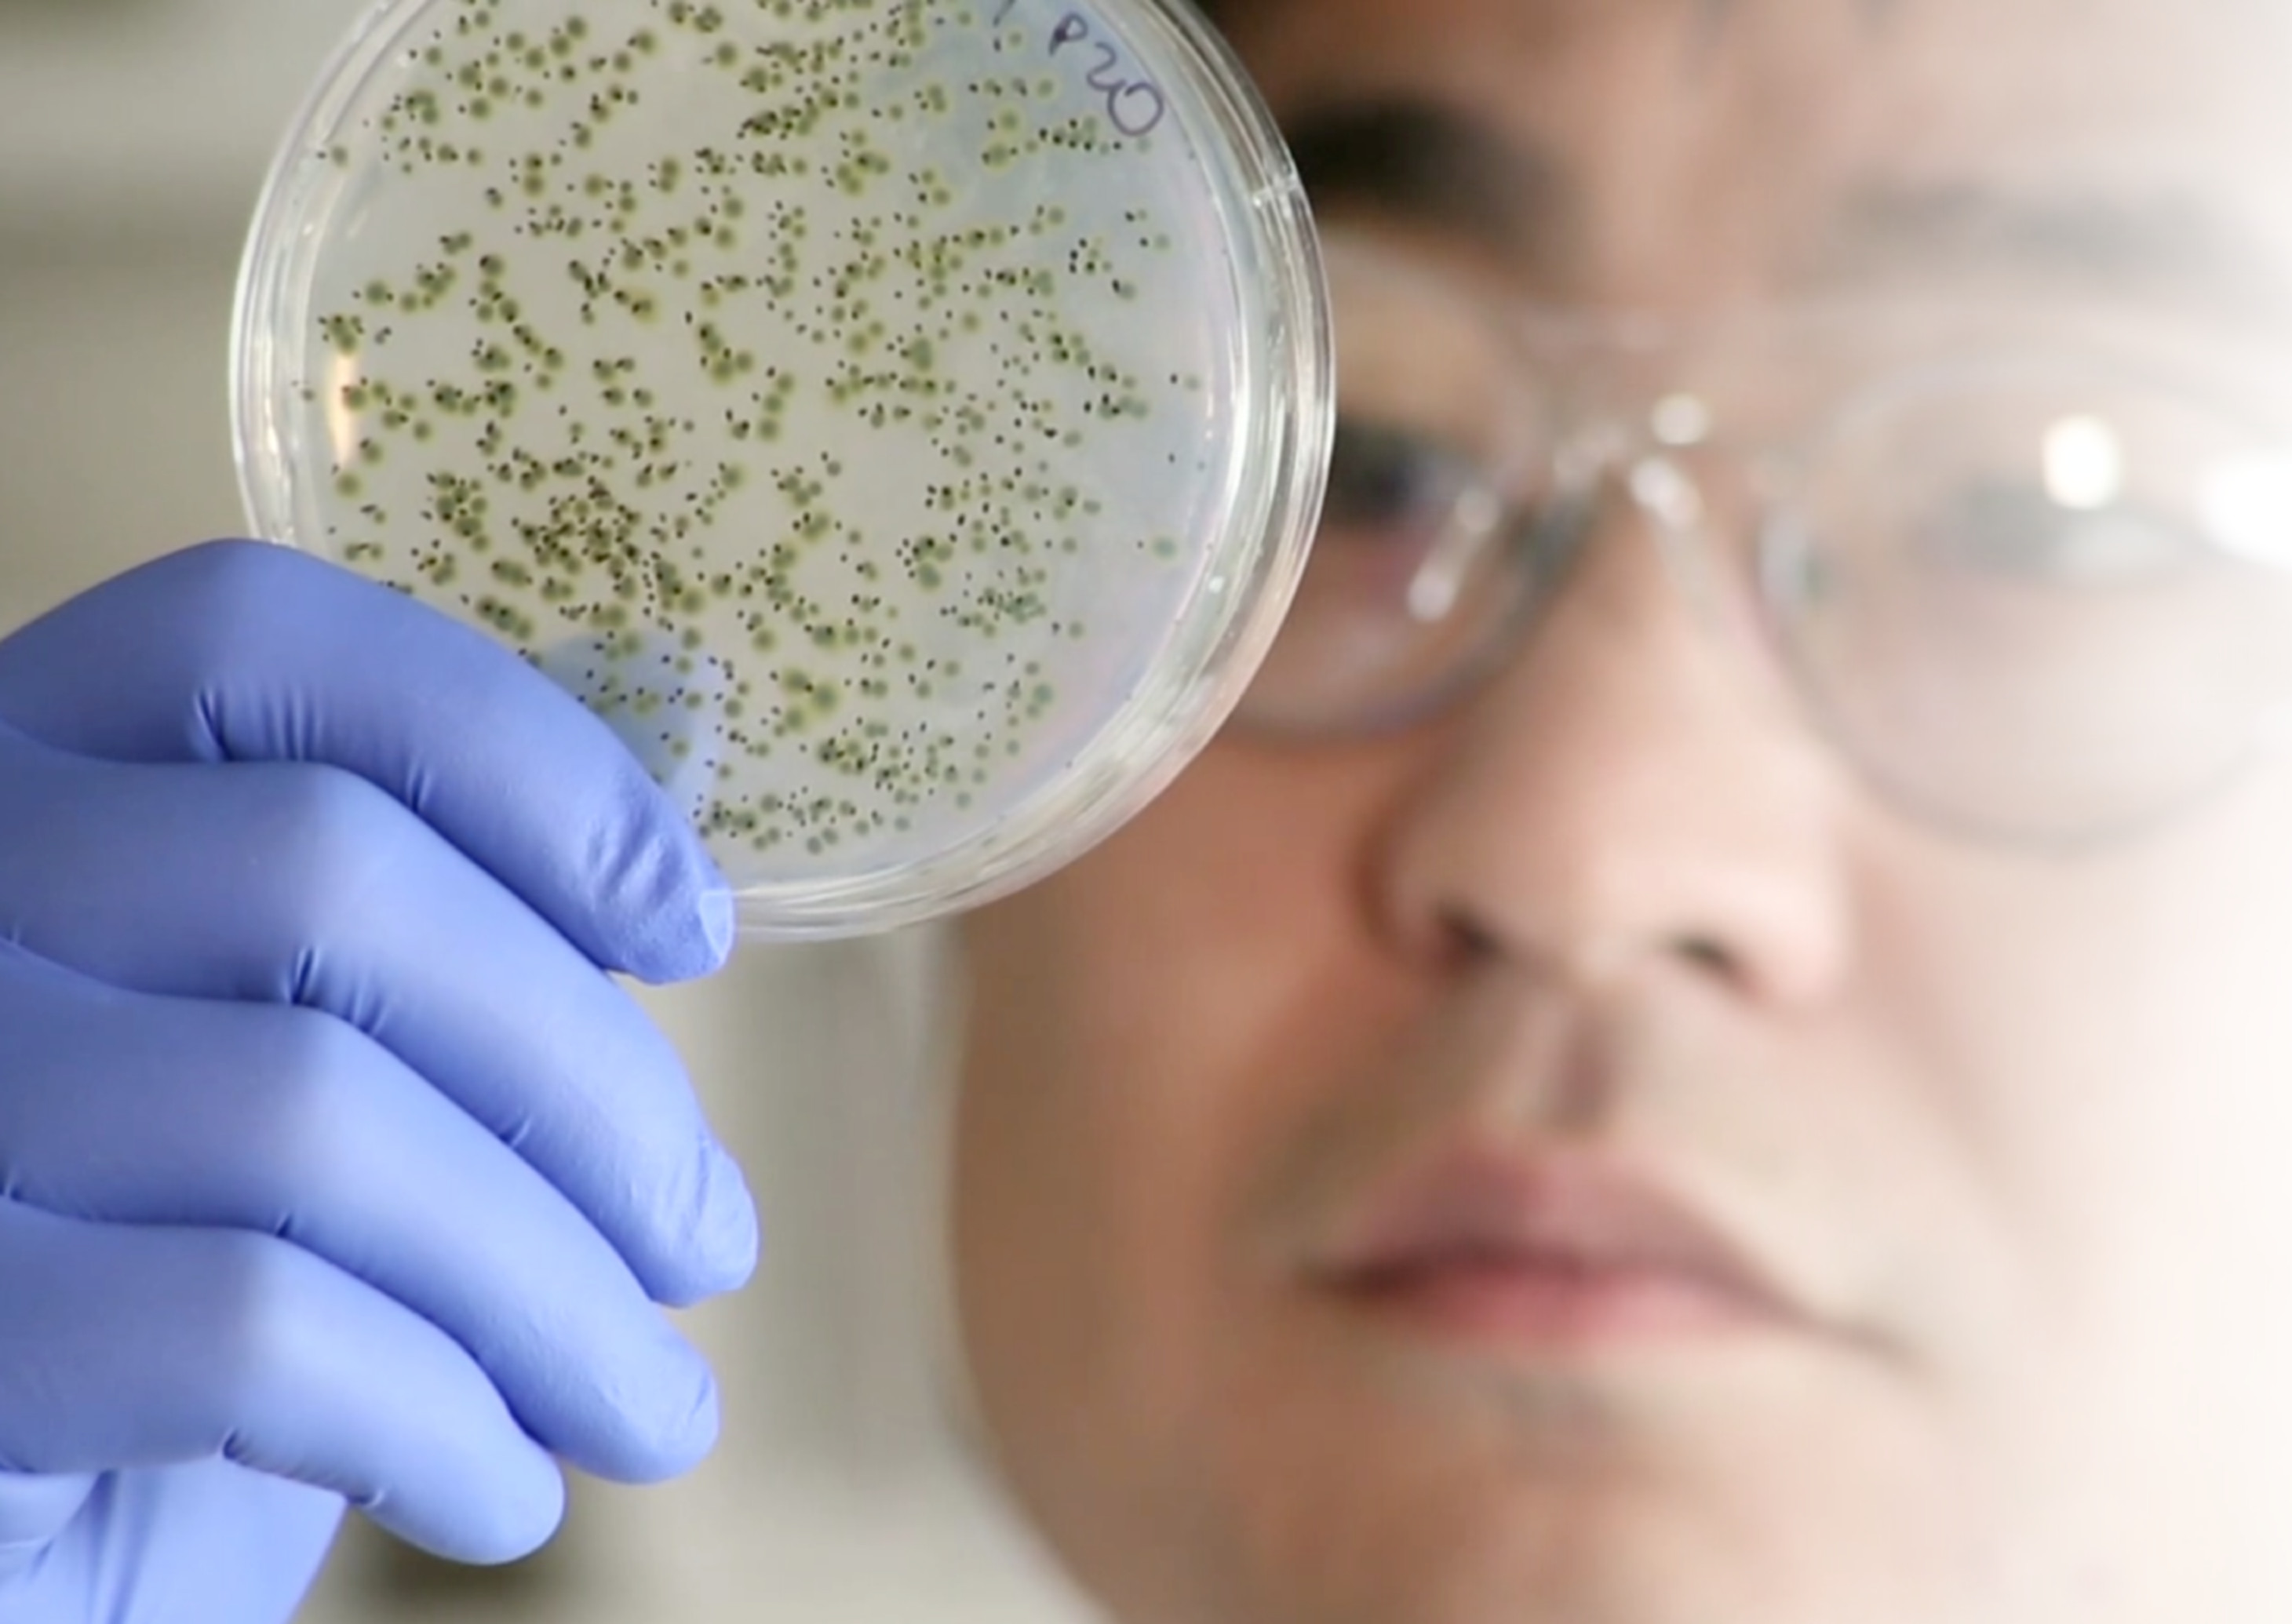
Scientist with petri dish

What Drives Us.
Vidala Labs is dedicated to pushing the boundaries of synthetic biology in the service of human health. We're building a more sustainable manufacturing method to democratize access to life-saving treatments worldwide.
pharmaceutical manufacturing for the future
Vidala Labs is dedicated to pushing the boundaries of synthetic biology in the service of human health. We're building a more sustainable manufacturing method to democratize access to life-saving treatments worldwide.